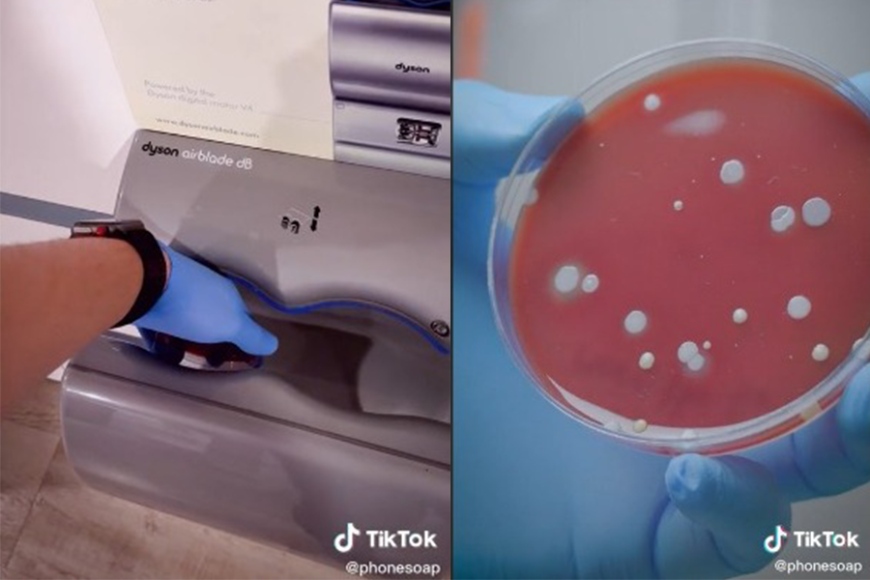

大家在公共厕所洗手后,通常都会使用纸巾擦手,还是使用烘干机把手吹干呢?近日,美国一家紫外线消毒器公司做了一项实验,他们分别到不同的公厕地点实测看看使用烘干机后会潜伏多少的细菌。

图片来源:新浪网
根据一名网友在TikTok上发布的视频,视频中可见他们使用了5个培养皿,并分别在不同的地点使用它们的烘干机,而其中一个培养皿则在被烘干机吹了之后,模拟洗手后将手上下晃动并让其自然干,另外四个则保持不变。
实验人员在这之后将5个培养皿放入培养箱里静待三天,通过对照后竟然出现了意想不到的结果:
经过上下晃动的培养皿:

首先,第一个培养皿在经过某间厕所的烘干机烘干后,实验人员模拟了人在洗手后将手上下晃动,待水自然干的场景,而这个经过晃动的培养皿在三天后发现,并没有培养出肉眼可见的细菌。
同个地点,并未经过上下晃动的培养皿:

第二个培养皿与第一个的地点一样,但这次的培养皿并未经过上下晃动。该培养皿放入培养器三天后竟然滋长出了肉眼可见的细菌,看起来相当恶心!
加油站的培养皿:

第三个培养皿使用了加油站的烘干机,结果也与第二个培养皿相同,肉眼可见的细菌滋长了起来。
电影院及商店的培养皿:

最后两个分别在使用了电影院及商店后的培养皿,虽然没有上述其他的培养皿细菌来的多,但也依然潜伏着细菌。
美国公司的实验人员在最后得出的结论是,使用了烘干机后将手上下晃动甩干水是最能避免细菌潜伏在手部的方式,不想使用烘干机的朋友也能使用纸巾擦拭,这也是最干净且最卫生的做法。

此视频在发布后于网络上疯传,短短两天变积累了650万观看次数。部分网友们看了后表示恶心及开始害怕使用烘干机,有的网友甚至表示:“烘干机吹出来的风曾被人形容成“上千个屁”,再也不敢使用烘干机了!”“我还是用衣服来弄干手好了。”
网友们也表示,疫情后的公厕多数都有着消毒液,以方便人们在时候公共设施后能够消毒手部。
@phonesoap How germy are hand air dryers…again?#PrimeDayDreamDeals #phonesoap ♬ original sound - PhoneSoap
看完后你还敢使用烘干机吗?
点我订阅88razzi Telegram追踪第一手时事新闻!
写稿也能赚钱!如果你也喜欢写或分享文章,那看这里就对了!透过88razzi的平台,把你的文章分享给更多人看到,还可以赚取外快!想要写稿赚钱就赶快点击这里投稿给我们吧!
*部分照片取自网络,内容皆由投稿员归有,若想参考请附加此文的链接。照片或文章如有侵犯版权问题请告知,谢谢!
